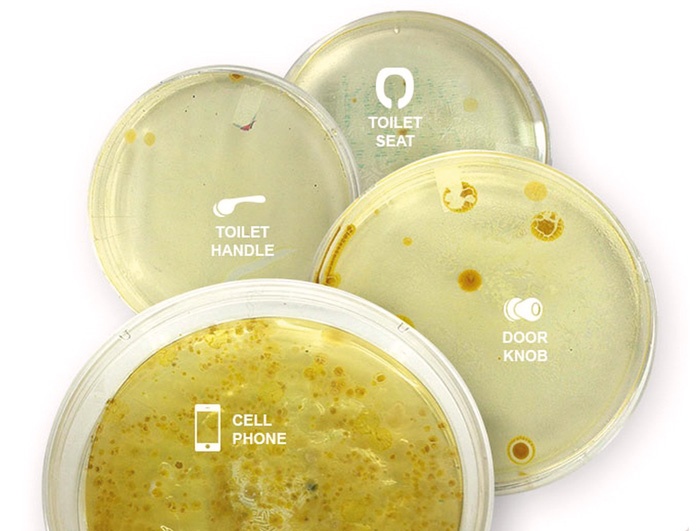

Žepno gojišče fekalnih bakterij
Vaš pametni telefon je bolj umazan, kot si mislite
Različno število bakterij: na ročaju od vrat, sedežu straniščne školjke, ročaju straniščnih vrat in na pametnem telefonu
© Profimedia, PhoneSoap
Ameriško raziskovalno podjetje Dscout je z raziskavo pogostosti rabe pametnih telefonov ugotovilo, da uporabniki telefonom vsak dan v povprečju namenimo kar 2617 dotikov. Za dotik sicer šteje vsakršna interakcija z napravo, torej vsak klik, swipe, tap in tipkanje črk, zato se te velikanske številke nikakor ne ustrašite preveč.
A vseeno: dejstvo je, da nam mobiteli sledijo na vsakem koraku, zato se pogosto pojavljajo tudi tam, kamor morda ne sodijo, denimo na stranišču. Po naročilu časnika Wall Street Journal je v Chicagu pred nedavnim potekala laboratorijska raziskava, v kateri so pametne telefone naključno izbranih uporabnikov testirali za prisotnost različnih bakterij in ugotovili, da je na čisto vseh testiranih vzorcih mrgolelo koliformnih bakterij, ki kažejo na fekalno onesnaženje. Če pa so fekalne bakterije na vašem telefonu, so prav tako na vaših dlaneh in prstih, s katerimi si manete oči.
Verjetno je razlog za prisotnost fekalij na telefonih ta, da smo preprosto packi in si rok ne umivamo dovolj pogosto. Neredko gre tudi za to, da si nekateri na stranišču očitno čas krajšamo prav s pametnimi telefoni; fekalne bakterije naj bi se nanje naseljevale takrat, ko potegnemo vodo, saj jih curek brezkompromisno razprši po bližnji okolici straniščne školjke. Ne glede na vzrok pa je skrb zbujajoča resničnost, da po rokah cele dneve valjamo naprave, ki zaradi aluminijastih detajlov in svetlečih se logotipov delujejo nedolžno čiste, pravzaprav pa so nagnusno umazane.
Pred leti je bila podobna raziskava opravljena na londonski univerzi: glede prisotnosti fekalij so testirali 390 pametnih telefonov. 95 odstotkov njihovih lastnikov je trdilo, da si roke umivajo redno, a izsledki raziskave tem trditvam odločno nasprotujejo. Pri kar 82 odstotkih telefonov so zaznali patogene bakterije, denimo bakterije E. coli, ki je bila prisotna kar na 16 odstotkih vzorcev. Fekalne bakterije so bile na vsakem šestem telefonu. Britancem je osebna higiena očitno bliže kot Američanom, a delčki ekskrementa tudi britanskim telefonom ne uidejo.
Po podatkih iz omenjenih raziskav naj bi bili pametni telefoni bolj umazani od sedišč straniščnih školjk. Navadno telefoniranje naj bi bilo torej skoraj tako ogabno, kot če bi se po obrazu drgnili s straniščno metlico.
Rešitev te težave se zdi precej očitna in preprosta: umivajte si roke, pa bo vse v redu. Če pa si pri opravljanju velike potrebe že morate krajšati čas, bi bila morda najelegantnejša rešitev preprosto ta, da na stranišču članke raje kot na telefonskih zaslonih berete v tiskani obliki, kar ne bo koristilo zgolj vaši osebni higieni, temveč tudi naši nakladi.
Draga bralka, dragi bralec. Kdor želi danes ohraniti trezno glavo, mora imeti dostop do kakovostnih informacij.
Svet je, žal, nasičen z informacijskim šumom, dobre in premišljene analize, komentarji, recenzije in napovedi pa so v Mladini dostopni zgolj naročnikom. Ta prispevek smo za vas izjemoma odklenili.
Naredite tudi vi kaj zase, postanite naš naročnik in preizkusite Mladinin učinek.